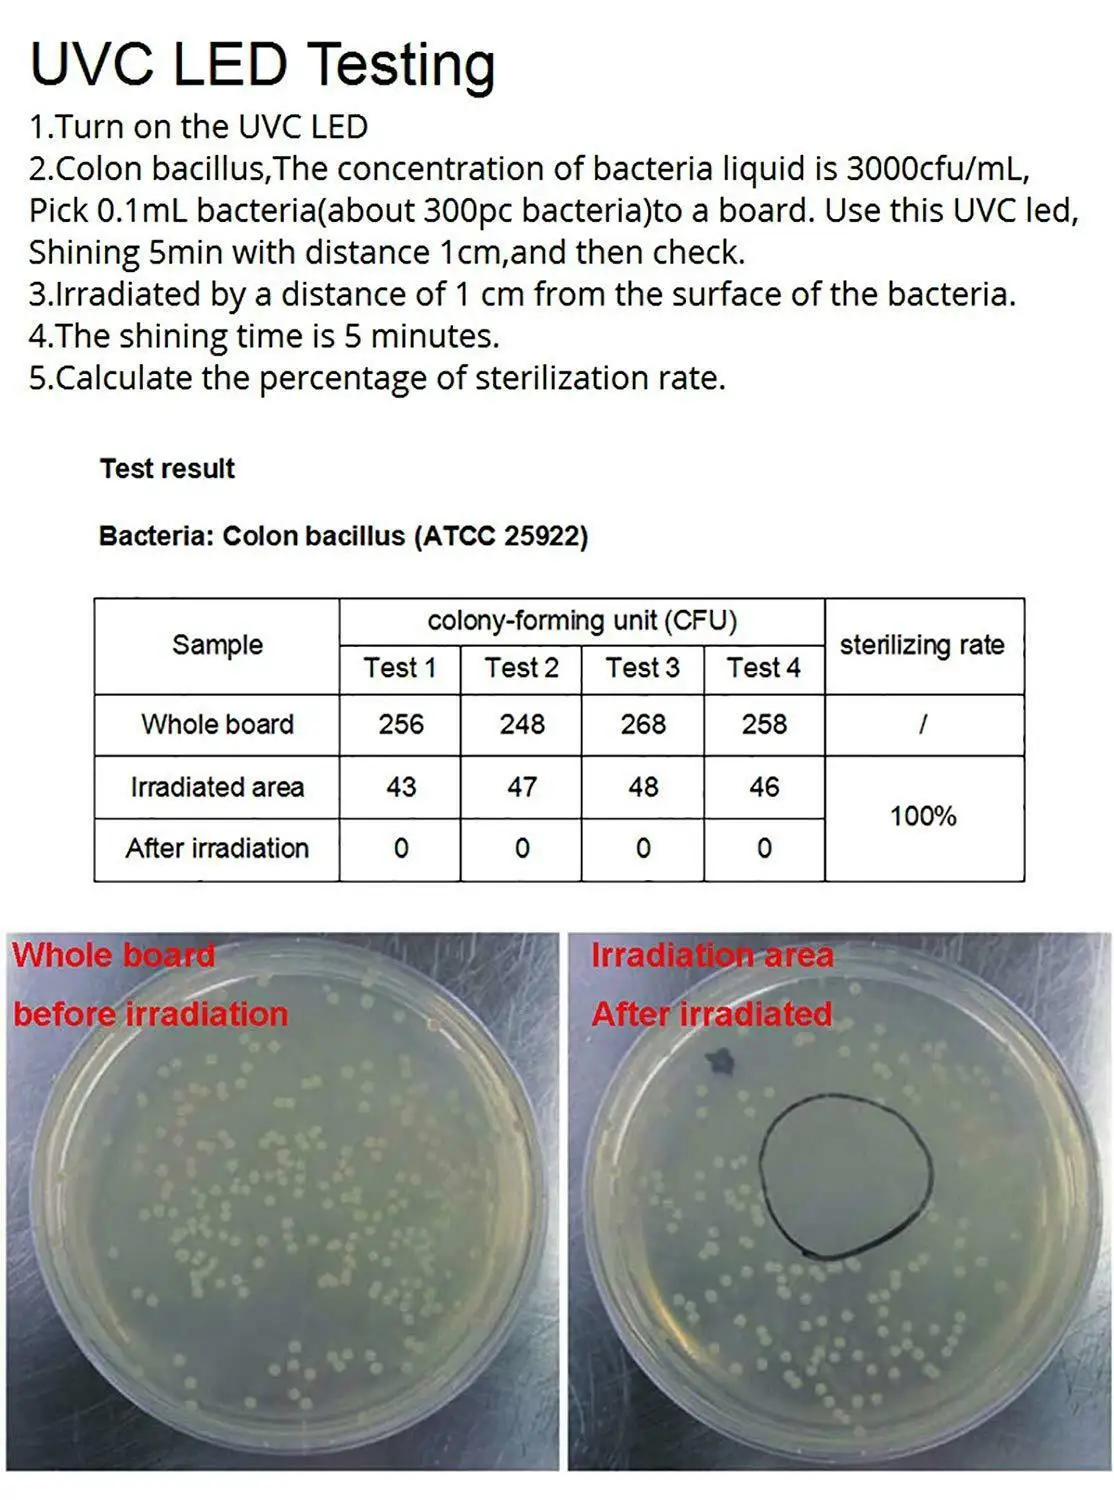
Lumiwell 275nm UV LED Lamp UVC LED Lamp DC12/24V Sterilizer DUV LED Ultra Violet lamp with cable XH

LIMITED EDITION Lumiwell 275nm UV LED Lamp UVC LED Lamp DC12/24V Sterilizer DUV LED Ultra Violet lamp with cable XH
Price : US $13.99 / Piece
Price after discount : US $12.59 / Piece
Get coupons Lumiwell 275nm UV LED Lamp UVC LED Lamp DC12/24V Sterilizer DUV LED Ultra Violet lamp with cable XH for cheap price to grab big discount, you can buy 2 piece LIMITED EDITION Lumiwell 275nm UV LED Lamp UVC LED Lamp DC12/24V Sterilizer DUV LED Ultra Violet lamp with cable XH then you get discount 10% OFF
Free Shipping Lumiwell 275nm UV LED Lamp UVC LED Lamp DC12/24V Sterilizer DUV LED Ultra Violet lamp with cable XH are attractive to buyers from around the world
OVERVIEW Product Lumiwell 275nm UV LED Lamp UVC LED Lamp DC12/24V Sterilizer DUV LED Ultra Violet lamp with cable XH
SPECIFICATIONS Product Lumiwell 275nm UV LED Lamp UVC LED Lamp DC12/24V Sterilizer DUV LED Ultra Violet lamp with cable XH
275nm 12mW DC12V UVC LED Tube for Water Tank Disinfection with Feedback Circuit
UV LED Module DC24V Water sterilizer UVC LED Lamp with Cable XH2.54 2P Terminal

Tidak ada komentar:
Posting Komentar